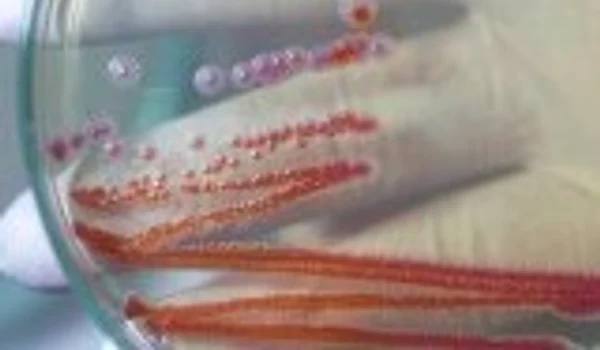
image

Protestul studenţilor de la Istorie se extinde la mai multe facultăţi
0
Studenţii de la Politehnica din Bucureşti s-au luat după colegii lor de la Facultatea de Istorie şi protestează împotriva bugetului mic pe care l-a primit Educaţia în 2012.
În plus, protestul studenţilor s-a extins în nouă centre universitare din ţară, unde tinerii au ocupat facultăţile pentru a dezbate cele mai importante probleme ale Educaţiei împreună cu profesorii lor. Prima temă: bugetul care este la jumătate faţă de ce prevede legea Educaţiei.
Reprezentanţii Uniunii Studenţilor din România susţin că protestul lor s-a extins pe fondul mişcării studenteşti care a avut loc joi, 24 noiembrie 2011, in cadrul Facultăţii de Istorie a Universităţii din Bucureşti.
"Noi vrem să atragem atenţia şi asupra modului în care conducerea universităţilor încearcă să împingă mişcarea studenţească spre obedienţă, atunci când studenţii aduc acuze incomode liderilor politici, asa cum s-a intamplat la Facultatea de Istorie din Bucureşti. În plus, noi sprijinim comunitatea universitară în demersurile care privesc acţiunile pentru un buget al educaţiei de cel puţin 6%, aşa cum s-a stipulat în Pactul Naţional Pentru Educaţie din anul 2008", a spus Ionuţ Poenaru, preşedintele UNSR.